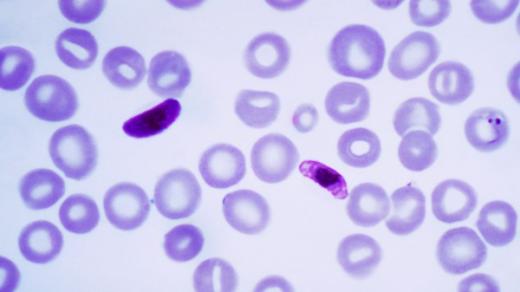
Nejnebezpečnějším původcem malárie je prvok zimnička tropická (Plasmodium falciparum), který se vyskytuje v tropech Afriky, Asie i Ameriky

Raymond Chandler: Vysoké okno. Ikonickou detektivku s Philem Marlowem čte Petr Lněnička
Četba na pokračování
Přejít k hlavnímu obsahu | Přejít k hlavnímu menu
Plus
Věda Plus | Český rozhlas

Raymond Chandler: Vysoké okno. Ikonickou detektivku s Philem Marlowem čte Petr Lněnička
Četba na pokračování

Jiří Hájíček: Dešťová hůl. Román o dávné lásce, rodné půdě a hledání pravdy v minulosti. Čte Jan Holík
Četba na pokračování

Kateřina Surmanová: O čem skály mlčí. Mystickou detektivku z Českého Švýcarska čte Aleš Procházka
Četba na pokračování

Zrůda s tváří dědečka. Vražda barmanky odstartovala závod s časem pro olomouckou kriminálku
Kriminálka
George Farquhar: Galantní lest. Hvězdně obsazená komedie o dvou zchudlých londýnských kavalírech
Hra pro pamětníky

Werner Fritsch: Enigma Emmy Göring. Hana Maciuchová v titulní roli nejlepší rozhlasové hry roku 2010
Hra na neděli
Plus

Každý den přinášíme nejnovější vědecké objevy a analýzy expertů a expertek. Osvětlujeme vědecká témata a hledáme odpovědi i na vaše otázky související se současnou civilizací. Vydejte se s námi na průzkum všech světů Země a ještě dál. Poslechněte si v rozhovorech, reportážích nebo živých vstupech, jak vědci a vědkyně uvažují o fenoménech rychle se měnícího světa.

Raymond Chandler: Vysoké okno. Ikonickou detektivku s Philem Marlowem čte Petr Lněnička
Četba na pokračování

Jiří Hájíček: Dešťová hůl. Román o dávné lásce, rodné půdě a hledání pravdy v minulosti. Čte Jan Holík
Četba na pokračování

Kateřina Surmanová: O čem skály mlčí. Mystickou detektivku z Českého Švýcarska čte Aleš Procházka
Četba na pokračování

Zrůda s tváří dědečka. Vražda barmanky odstartovala závod s časem pro olomouckou kriminálku
Kriminálka
George Farquhar: Galantní lest. Hvězdně obsazená komedie o dvou zchudlých londýnských kavalírech
Hra pro pamětníky

Werner Fritsch: Enigma Emmy Göring. Hana Maciuchová v titulní roli nejlepší rozhlasové hry roku 2010
Hra na neděli

Nové léky dávají naději ženám s autoimunitním onemocněním jater PBC
Věda Plus

Role dědičnosti u vzniku rakoviny
Lékárna

Martin Fendrych: Češi jsou zvyklí na všechno nadávat, ale screeningů máme snad nejvíc na světě
Názory a argumenty

Jak chtějí Češi léčit rakovinu
Vinohradská 12

Genová terapie: unikátní novinka v onkologii. Personalizovaná léčba očima odbornice i pacienta
Moci bez nemoci

ZÁZRAKY MEDICÍNY: Chirurgie se už obejde bez velkých řezů,...
Dopolední Radiožurnál

Preventivní léky před nákazou HIV jsou v Česku dostupné. Jen se o tom málo ví, zdůrazňuje lékař
Leonardo Plus
Američtí vědci rozluštili genom parazita způsobujícího malárii. Objev může přinést účinnější léky
Dnešní Plus

Čeští vědci jezdí do Kamerunu objevovat zázračné stromy. Mohou pomoct i proti rakovině
Magazín Experiment

Prezident lékárnické komory: Apeluji na všechny, aby léky neskupovali. Nejvíc chybí antibiotika
Dvacet minut Radiožurnálu